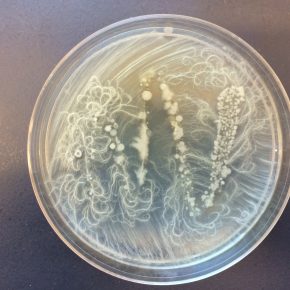
img_3885

On a recent Friday afternoon, nearly 20 artists gathered in a microbiology lab to listen as graduate students presented their work. After hearing descriptions of “cheating microbes” and “murderous bacteria,” it was the artists’ turn to do some science. They put on white coats, blue latex gloves, and examined petri dishes with such titles as “dirt” and “Emy’s mouth.”
On a recent Friday afternoon, nearly 20 artists gathered in a microbiology lab to listen as graduate students presented their work. After hearing descriptions of “cheating microbes” and “murderous bacteria,” it was the artists’ turn to do some science. They put on white coats, blue latex gloves, and examined petri dishes with such titles as “dirt” and “Emy’s mouth.”
The artists were visiting the lab as part of a collaboration between Corvallis Arts Center, Spring Creek Project, OSU’s Department of Microbiology, and SPARK—the university’s year-long celebration of art/science connections. Known as Microbiomes: To See the Unseen, this effort will result in an art and writing exhibition at the Corvallis Arts Center.
Several artists at the workshop grew up with connections to science while others simply hold a deep belief in the ultimate human purpose of science.
Take Kim Campbell for instance. Campbell, a photographer from Portland who was using white microbes to paint on a petri dish, said she spent time as a child in the lab with her scientist father.
“I went in the opposite direction, but I am always interested in seeing things you can’t see with the naked eye,” she said.
Similarly, workshop leader Dr. Jerri Bartholomew, head of OSU’s Microbiology Department, has long been a proponent of making connections between art and science. She reminded the group that historically, Victorian scientists also had to be accomplished artists, and she noted that both art and science share an interest in process.
As both an expert of salmon disease and an artist of glass who keeps books of bio-inspired art in her office, Bartholomew attests that “with glass, every piece is an experiment. It’s the same way in science. You have to write down what you’re doing—record it and learn from it.”
Bartholomew said that when she was in grad school, students were expected to focus exclusively on science and that anything else was seen as a waste of time. Now, she sees science as placing greater value on outreach.
“Your end goal as a Ph.D. student is to produce three publications, and there’s a one-in-a-million chance of those reaching the general public,” Bartholomew said. “Very few people in your field will even read your papers. If you want your research to be relevant, you have to find a way to expand your audience.”
Bartholomew explained that speaking to a lay audience at events like the artist workshop is good practice for her students. In fact, “students need that challenge” because they must translate a language that can otherwise feel inaccessible, she believes.
The good news is that if you are an artist or writer, the Microbiomes show is accepting wonderful works through Thursday, Dec. 1. If you love art, science, or both, this event is right up your alley. If on top of that you love to educate and be educated, then Christmas is coming early this year.
Well… the bad news is that the exhibition is not scheduled until April and May 2017.
Submission details for visual artists are online at the Corvallis Arts Center website, www.theartcenter.net, and for writers through The Spring Creek project, www.blogs.oregonstate.edu/
By Maggie Anderson
Do you have a story for The Advocate? Email editor@corvallisadvocate.com

